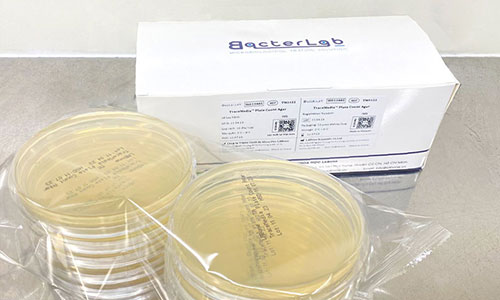
Đĩa - Plate

MÔI TRƯỜNG VI SINH
LABone cung cấp thiết bị và giải pháp chuyên dụng cho lĩnh vực vi sinh như lâm sàng, an toàn thực phẩm, dược phẩm, mỹ phẩm và các thiết bị vi sinh.

Đĩa - Plate

Chai

Túi


LABone cung cấp thiết bị và giải pháp chuyên dụng cho lĩnh vực vi sinh như lâm sàng, an toàn thực phẩm, dược phẩm, mỹ phẩm và các thiết bị vi sinh.